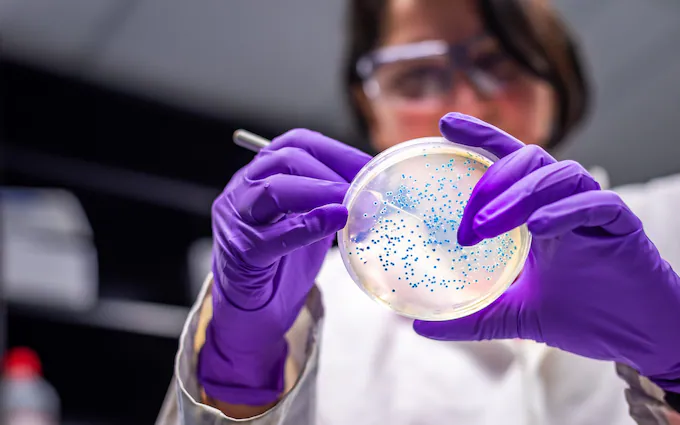
Drug-Resistant Superbugs Could Kill 39 Million by 2050, New Study Warns

A groundbreaking global analysis released on Monday projects that drug-resistant superbugs could cause nearly 40 million deaths over the next 25 years if current trends continue. Researchers are calling for urgent action to address this escalating health threat.
Superbugs—bacteria and pathogens resistant to antibiotics—have increasingly become a global health challenge. The study, published in The Lancet, represents the first comprehensive attempt to track the future impact of antimicrobial resistance (AMR) on a global scale.
Between 1990 and 2021, more than one million people died each year from infections caused by superbugs. While deaths among children under five have decreased by over 50% in the past three decades due to improved infection control measures, superbugs in this age group remain difficult to treat. Conversely, deaths among individuals aged 70 and over have surged by more than 80%, reflecting the growing vulnerability of an ageing population.
The study highlighted a dramatic increase in deaths from methicillin-resistant Staphylococcus aureus (MRSA), which doubled to 130,000 in 2021 compared to three decades earlier.
Using predictive modelling, the researchers estimated that direct deaths from AMR could rise by 67% to nearly two million annually by 2050. AMR is expected to contribute to an additional 8.2 million deaths each year, marking a nearly 75% increase. If these trends continue, superbugs could directly cause 39 million deaths over the next 25 years and contribute to a total of 169 million deaths.
However, the study also outlined more optimistic scenarios. By improving treatment for severe infections and enhancing access to antimicrobial drugs, it is possible to save up to 92 million lives by 2050.
The research examined 22 pathogens, 84 drug-pathogen combinations, and 11 infectious syndromes, analyzing data from 520 million individual records across 204 countries and territories. The findings are being presented ahead of a high-level UN meeting on AMR scheduled for September 26.
While antimicrobial resistance is a natural occurrence, the overuse and misuse of antibiotics in humans, animals, and plants have exacerbated the problem.
Trending